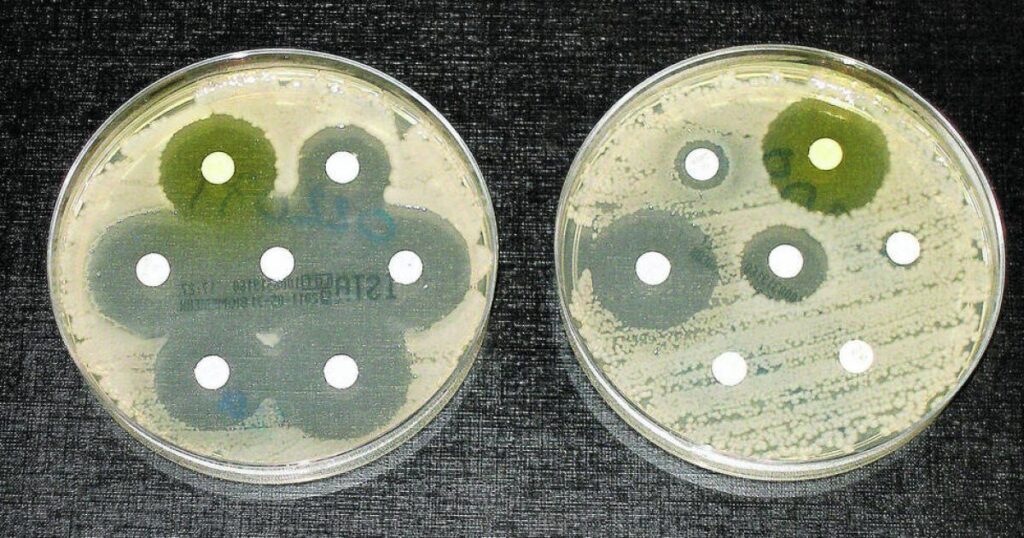

Entre los años 2018 y 2023 se ha observado un incremento del 40% en la resistencia de las bacterias frente a los antibióticos, según los últimos informes de la Organización Mundial de la Salud (OMS). Esto equivale a un aumento anual medio que oscila entre el 5 % y el 15 %. Esta tendencia, impulsada en gran parte por el uso inadecuado de estos medicamentos, sitúa a la resistencia antimicrobiana como una de las amenazas de salud pública más graves a nivel global.
Datos clave del informe GLASS
El reporte más reciente proviene del sistema GLASS —una plataforma de vigilancia de la OMS especializada en resistencia antimicrobiana— y revela que, entre los casos monitoreados, una de cada seis infecciones bacterianas demuestra ya resistencia a los antibióticos convencionales.
El problema es particularmente grave en algunas regiones del mundo: en África, el 20 % de las infecciones evaluadas mostraron resistencia; en Asia y Oriente Medio, esa proporción asciende al 33 %.
Para llegar a estas conclusiones, los investigadores analizaron hasta 22 antibióticos de uso común, aplicados a infecciones urinarias, gastrointestinales, sanguíneas o de transmisión sexual (como la gonorrea).
Asimismo, examinaron ocho familias de bacterias habituales en estos cuadros: entre ellas destacan la Escherichia coli, Salmonella, Staphylococcus aureus y Streptococcus pneumoniae.
Organismos que más desafían los tratamientos
Dos bacterias han llamado especialmente la atención de los científicos por su elevada resistencia: E. coli y Klebsiella pneumoniae. Más de un 40 % de las cepas de E. coli evaluadas mostraron resistencia frente a cefalosporinas de tercera generación. En el caso de K. pneumoniae, esa cifra se eleva hasta el 55 %.
Este panorama obliga a recurrir a antibióticos de último recurso, muchos de ellos más costosos o menos accesibles, lo que premia aún más a los sistemas de salud con recursos limitados.
Impacto mortal
La resistencia antimicrobiana —un fenómeno que incluye bacterias resistentes, así como virus frente a antivirales o hongos frente a antifúngicos— está asociada con casi 5 millones de muertes al año. De esa cifra, se estima que alrededor de 1,27 millones de personas mueren directamente por infecciones que resistieron los tratamientos habituales.
El director general de la OMS, Tedros Adhanom Ghebreyesus, advirtió durante la presentación del informe que “la resistencia a los antimicrobianos está creciendo más rápido que los avances de la medicina moderna”.
Respuestas, retos y recomendaciones
Como nota positiva, el informe destaca que 104 países participaron en esta ronda del sistema GLASS, frente a los 25 que lo hacían en 2016, aunque aún falta que casi la mitad de los estados miembros se sumen a la vigilancia.
La OMS insiste en que una estrategia esencial para frenar este avance es evitar el uso indiscriminado de antibióticos. Los pacientes —y el público en general— no deben asumir que una fiebre u otro síntoma son sinónimo de antibiótico; deben confiar en el diagnóstico profesional.
Además, la organización subraya que las vacunas y las normas básicas de higiene —como el lavado frecuente de manos— son herramientas valiosas para prevenir las infecciones bacterianas.
Entre las dificultades estructurales que plantea esta batalla se encuentra la crisis financiera de la OMS, agravada entre otros factores por la salida de Estados Unidos de la organización. Esto ha obligado a recortar recursos destinados al estudio de la resistencia antimicrobiana.
También se lamenta la reciente clausura del Fleming Fund, un programa del Reino Unido dedicado al fomento de capacidades en vigilancia antimicrobiana.